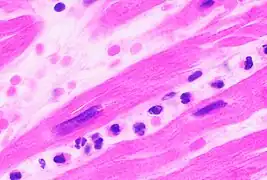
Neutrophils are seen in a myocardial infarction at approximately 12–24 hours, as seen in this micrograph.

Neutrophil
| Neutrophil | |
|---|---|
.png) 3D rendering of a neutrophil | |
 Neutrophils with segmented nuclei surrounded by erythrocytes and platelets. Intra-cellular granules are visible in the cytoplasm (Giemsa stained). | |
| Details | |
| System | Immune system |
| Function | Phagocytosis |
| Identifiers | |
| MeSH | D009504 |
| TH | H2.00.04.1.02012 |
| FMA | 62860 |
| Anatomical terms of microanatomy | |
Neutrophils are a type of phagocytic white blood cell and part of innate immunity. More specifically, they form the most abundant type of granulocytes and make up 40% to 70% of all white blood cells in humans.[1] Their functions vary in different animals.[2] They are also known as neutrocytes, heterophils or polymorphonuclear leukocytes.
They are formed from stem cells in the bone marrow and differentiated into subpopulations of neutrophil-killers and neutrophil-cagers. They are short-lived (between 5 and 135 hours, see § Life span) and highly mobile, as they can enter parts of tissue where other cells/molecules cannot. Neutrophils may be subdivided into segmented neutrophils and banded neutrophils (or bands). They form part of the polymorphonuclear cells family (PMNs) together with basophils and eosinophils.[3][4][5]
The name neutrophil derives from staining characteristics on hematoxylin and eosin (H&E) histological or cytological preparations. Whereas basophilic white blood cells stain dark blue and eosinophilic white blood cells stain bright red, neutrophils stain a neutral pink. Normally, neutrophils contain a nucleus divided into 2–5 lobes.[6]
Neutrophils are a type of phagocyte and are normally found in the bloodstream. During the beginning (acute) phase of inflammation, particularly as a result of bacterial infection, environmental exposure,[7] and some cancers,[8][9] neutrophils are one of the first responders of inflammatory cells to migrate toward the site of inflammation. They migrate through the blood vessels and then through interstitial space, following chemical signals such as interleukin-8 (IL-8), C5a, fMLP, leukotriene B4, and hydrogen peroxide (H2O2)[10] in a process called chemotaxis. They are the predominant cells in pus, accounting for its whitish/yellowish appearance.[11]
Neutrophils are recruited to the site of injury within minutes following trauma and are the hallmark of acute inflammation.[12] They not only play a central role in combating infection but also contribute to pain in the acute period by releasing pro-inflammatory cytokines and other mediators that sensitize nociceptors, leading to heightened pain perception.[13] However, due to some pathogens being indigestible, they may not be able to resolve certain infections without the assistance of other types of immune cells.
Structure


When adhered to a surface, neutrophil granulocytes have an average diameter of 12–15 micrometers (μm) in peripheral blood smears. In suspension, human neutrophils have an average diameter of 8.85 μm.[14]
With the eosinophil and the basophil, they form the class of polymorphonuclear cells, named for the nucleus' multilobulated shape (as compared to lymphocytes and monocytes, the other types of white cells). The nucleus has a characteristic lobed appearance, the separate lobes connected by chromatin. The nucleolus disappears as the neutrophil matures, which is something that happens in only a few other types of nucleated cells.[15]: 168 Up to 17% of female human neutrophil nuclei have a drumstick-shaped appendage which contains the inactivated X chromosome.[16] In the cytoplasm, the Golgi apparatus is small, mitochondria and ribosomes are sparse, and the rough endoplasmic reticulum is absent.[15]: 170 The cytoplasm also contains about 200 granules, of which a third are azurophilic.[15]: 170
Neutrophils will show increasing segmentation (many segments of the nucleus) as they mature. A normal neutrophil should have 3–5 segments. Hypersegmentation is not normal but occurs in some disorders, most notably vitamin B12 deficiency. This is noted in a manual review of the blood smear and is positive when most or all of the neutrophils have 5 or more segments.

Neutrophils are the most abundant white blood cells in the human body (approximately 1011 are produced daily); they account for approximately 50–70% of all white blood cells (leukocytes). The stated normal range for human blood counts varies between laboratories, but a neutrophil count of 2.5–7.5 × 109/L is a standard normal range. People of African and Middle Eastern descent may have lower counts, which are still normal.[17] A report may divide neutrophils into segmented neutrophils and bands.
When circulating in the bloodstream and inactivated, neutrophils are spherical. Once activated, they change shape and become more amorphous or amoeba-like and can extend pseudopods as they hunt for antigens.[18]
The capacity of neutrophils to engulf bacteria is reduced when simple sugars like glucose, fructose as well as sucrose, honey and orange juice were ingested, while the ingestion of starches had no effect. Fasting, on the other hand, strengthened the neutrophils' phagocytic capacity to engulf bacteria. It was concluded that the function, and not the number, of phagocytes in engulfing bacteria was altered by the ingestion of sugars.[19] In 2007 researchers at the Whitehead Institute of Biomedical Research found that given a selection of sugars on microbial surfaces, the neutrophils reacted to some types of sugars preferentially. The neutrophils preferentially engulfed and killed beta-1,6-glucan targets compared to beta-1,3-glucan targets.[20][21]
Development
Life span

The average lifespan of inactivated human neutrophils in the circulation has been reported by different approaches to be between 5 and 135 hours.[22][23]
Upon activation, they marginate (position themselves adjacent to the blood vessel endothelium) and undergo selectin-dependent capture followed by integrin-dependent adhesion in most cases, after which they migrate into tissues, where they survive for 1–2 days.[24] Neutrophils have also been demonstrated to be released into the blood from a splenic reserve following myocardial infarction.[25]
The distribution ratio of neutrophils in bone marrow, blood and connective tissue is 28:1:25.
Neutrophils are much more numerous than the longer-lived monocyte/macrophage phagocytes. A pathogen (disease-causing microorganism or virus) is likely to first encounter a neutrophil. Some experts hypothesize that the short lifetime of neutrophils is an evolutionary adaptation. The short lifetime of neutrophils minimizes propagation of those pathogens that parasitize phagocytes (e.g. Leishmania[26]) because the more time such parasites spend outside a host cell, the more likely they will be destroyed by some component of the body's defenses. Also, because neutrophil antimicrobial products can also damage host tissues, their short life limits damage to the host during inflammation.[24]
Neutrophils will be removed after phagocytosis of pathogens by macrophages. PECAM-1 and phosphatidylserine on the cell surface are involved in this process.
Function
Chemotaxis
Neutrophils undergo a process called chemotaxis via amoeboid movement, which allows them to migrate toward sites of infection or inflammation. Cell surface receptors allow neutrophils to detect chemical gradients of molecules such as interleukin-8 (IL-8), interferon gamma (IFN-γ), C3a, C5a, and leukotriene B4, which these cells use to direct the path of their migration.
Neutrophils have a variety of specific receptors, including ones for complement, cytokines like interleukins and IFN-γ, chemokines, lectins, and other proteins. They also express receptors to detect and adhere to endothelium and Fc receptors for opsonin.[27]
In leukocytes responding to a chemoattractant, the cellular polarity is regulated by activities of small Ras or Rho guanosine triphosphatases (Ras or Rho GTPases) and the phosphoinositide 3-kinases (PI3Ks). In neutrophils, lipid products of PI3Ks regulate activation of Rac1, hematopoietic Rac2, and RhoG GTPases of the Rho family and are required for cell motility. Ras-GTPases and Rac-GTPases regulate cytoskeletal dynamics and facilitate neutrophils adhesion, migration, and spreading.[28][29][30] They accumulate asymmetrically to the plasma membrane at the leading edge of polarized cells. Spatially regulating Rho GTPases and organizing the leading edge of the cell, PI3Ks and their lipid products could play pivotal roles in establishing leukocyte polarity, as compass molecules that tell the cell where to crawl.
It has been shown in mice that in certain conditions neutrophils have a specific type of migration behaviour referred to as neutrophil swarming during which they migrate in a highly coordinated manner and accumulate and cluster to sites of inflammation.[31]
Anti-microbial function
Being highly motile, neutrophils quickly congregate at a focus of infection, attracted by cytokines expressed by activated endothelium, mast cells, and macrophages. Neutrophils express[32] and release cytokines, which in turn amplify inflammatory reactions by several other cell types.
In addition to recruiting and activating other cells of the immune system, neutrophils play a key role in the front-line defense against invading pathogens, and contain a broad range of proteins.[33] Neutrophils have three methods for directly attacking microorganisms: phagocytosis (ingestion), degranulation (release of soluble anti-microbials), and generation of neutrophil extracellular traps (NETs).[34]
Phagocytosis

Neutrophils are phagocytes, capable of ingesting microorganisms or particles. For targets to be recognized, they must be coated in opsonins – a process known as antibody opsonization.[18] They can internalize and kill many microbes, each phagocytic event resulting in the formation of a phagosome into which reactive oxygen species and hydrolytic enzymes are secreted. The consumption of oxygen during the generation of reactive oxygen species has been termed the "respiratory burst", although unrelated to respiration or energy production.
The respiratory burst involves the activation of the enzyme NADPH oxidase, which produces large quantities of superoxide, a reactive oxygen species. Superoxide decays spontaneously or is broken down via enzymes known as superoxide dismutases (Cu/ZnSOD and MnSOD), to hydrogen peroxide, which is then converted to hypochlorous acid (HClO), by the green heme enzyme myeloperoxidase. It is thought that the bactericidal properties of HClO are enough to kill bacteria phagocytosed by the neutrophil, but this may instead be a step necessary for the activation of proteases.[35]
Though neutrophils can kill many microbes, the interaction of neutrophils with microbes and molecules produced by microbes often alters neutrophil turnover. The ability of microbes to alter the fate of neutrophils is highly varied, can be microbe-specific, and ranges from prolonging the neutrophil lifespan to causing rapid neutrophil lysis after phagocytosis. Chlamydia pneumoniae and Neisseria gonorrhoeae have been reported to delay neutrophil apoptosis.[36][37][38] Thus, some bacteria – and those that are predominantly intracellular pathogens – can extend the neutrophil lifespan by disrupting the normal process of spontaneous apoptosis and/or PICD (phagocytosis-induced cell death). On the other end of the spectrum, some pathogens such as Streptococcus pyogenes are capable of altering neutrophil fate after phagocytosis by promoting rapid cell lysis and/or accelerating apoptosis to the point of secondary necrosis.[39][40]
Degranulation
Neutrophils also release an assortment of proteins in three types of granules by a process called degranulation. The contents of these granules have antimicrobial properties, and help combat infection. Glitter cells are polymorphonuclear leukocyte neutrophils with granules.[41] Degranulation is postulated to occur in a hierarchical manner, with the sequential release of secretory vesicles, tertiary granules, specific granules, and azurophilic granules in response to increasing intracellular calcium concentrations.[42] The release of neutrophils by degranulation occurs through exocytosis, regulated by exocytotic machinery including SNARE proteins, RAC2, RAB27, and others.
| Granule type | Protein |
|---|---|
| Azurophilic granules (or "primary granules") | Myeloperoxidase, bactericidal/permeability-increasing protein (BPI), defensins, and the serine proteases neutrophil elastase, Proteinase 3 and cathepsin G |
| Specific granules (or "secondary granules") | Alkaline phosphatase, lysozyme, NADPH oxidase, collagenase, lactoferrin, histaminase,[43] and cathelicidin |
| Tertiary granules | Cathepsin, gelatinase, and collagenase |
Neutrophil extracellular traps
In 2004, Brinkmann and colleagues described a striking observation that activation of neutrophils causes the release of web-like structures of DNA; this represents a third mechanism for killing bacteria.[44] These neutrophil extracellular traps (NETs) comprise a web of fibers composed of chromatin and serine proteases[45] that trap and kill extracellular microbes. It is suggested that NETs provide a high local concentration of antimicrobial components and bind, disarm, and kill microbes independent of phagocytic uptake. In addition to their possible antimicrobial properties, NETs may serve as a physical barrier that prevents further spread of pathogens. Trapping of bacteria may be a particularly important role for NETs in sepsis, where NETs are formed within blood vessels.[46] Finally, NET formation has been demonstrated to augment macrophage bactericidal activity during infection.[47][48] Recently, NETs have been shown to play a role in inflammatory diseases, as NETs could be detected in preeclampsia, a pregnancy-related inflammatory disorder in which neutrophils are known to be activated.[49] Neutrophil NET formation may also impact cardiovascular disease, as NETs may influence thrombus formation in coronary arteries.[50][51] NETs are now known to exhibit pro-thrombotic effects both in vitro[52] and in vivo.[53][54] More recently, in 2020 NETs were implicated in the formation of blood clots in cases of severe COVID-19.[55]
Tumor Associated Neutrophils (TANS)
TANs can exhibit an elevated extracellular acidification rate when there is an increase in glycolysis levels.[56] When there is a metabolic shift in TANs this can lead to tumor progression in certain areas of the body, such as the lungs. TANs support the growth and progression of tumors unlike normal neutrophils which would inhibit tumor progression through the phagocytosis of tumor cells. Utilizing a mouse model, they identified that both Glut1 and glucose metabolism increased in TANs found within a mouse who possessed lung adenocarcinoma.[56] A study showed that lung tumor cells can remotely initiate osteoblasts and these osteoblasts can worsen tumors in two ways. First, they can induce SiglecFhigh-expressing neutrophil formation that in turn promotes lung tumor growth and progression. Second, the osteoblasts can promote bone growth thus forming a favorable environment for tumor cells to grow to form bone metastasis.[57]
Clinical significance

Low neutrophil counts are termed neutropenia. This can be congenital (developed at or before birth) or it can develop later, as in the case of aplastic anemia or some kinds of leukemia. It can also be a side-effect of medication, most prominently chemotherapy. Neutropenia makes an individual highly susceptible to infections. It can also be the result of colonization by intracellular neutrophilic parasites.
In alpha 1-antitrypsin deficiency, the important neutrophil elastase is not adequately inhibited by alpha 1-antitrypsin, leading to excessive tissue damage in the presence of inflammation – the most prominent one being emphysema. Negative effects of elastase have also been shown in cases when the neutrophils are excessively activated (in otherwise healthy individuals) and release the enzyme in extracellular space. Unregulated activity of neutrophil elastase can lead to disruption of pulmonary barrier showing symptoms corresponding with acute lung injury.[58] The enzyme also influences activity of macrophages by cleaving their toll-like receptors (TLRs) and downregulating cytokine expression by inhibiting nuclear translocation of NF-κB.[59]
In Familial Mediterranean fever (FMF), a mutation in the pyrin (or marenostrin) gene, which is expressed mainly in neutrophil granulocytes, leads to a constitutively active acute-phase response and causes attacks of fever, arthralgia, peritonitis, and – eventually – amyloidosis.[60]
Hyperglycemia can lead to neutrophil dysfunction. Dysfunction in the neutrophil biochemical pathway myeloperoxidase as well as reduced degranulation are associated with hyperglycemia.[61]
The Absolute neutrophil count (ANC) is also used in diagnosis and prognosis. ANC is the gold standard for determining severity of neutropenia, and thus neutropenic fever. Any ANC < 1500 cells / mm3 is considered neutropenia, but <500 cells / mm3 is considered severe.[62] There is also new research tying ANC to myocardial infarction as an aid in early diagnosis.[63][64] Neutrophils promote ventricular tachycardia in acute myocardial infarction.[65]
In autopsy, the presence of neutrophils in the heart or brain is one of the first signs of infarction, and is useful in the timing and diagnosis of myocardial infarction and stroke.
Neutrophils are seen in a myocardial infarction at approximately 12–24 hours,[66] as seen in this micrograph.
Neutrophils are seen in a myocardial infarction at approximately 12–24 hours,[66] as seen in this micrograph.
Pathogen evasion and resistance
Just like phagocytes, pathogens may evade or infect neutrophils.[68] Some bacterial pathogens evolved various mechanisms such as virulence molecules to avoid being killed by neutrophils. These molecules collectively may alter or disrupt neutrophil recruitment, apoptosis or bactericidal activity.[68]
Neutrophils can also serve as host cell for various parasites that infects them avoding phagocytosis, including:
- Leishmania major – uses neutrophils as vehicle to parasitize phagocytes[26]
- M. tuberculosis[69]
- M. leprae[69]
- Yersinia pestis[69]
- Chlamydia pneumoniae[69]
Neutrophil antigens
There are five (HNA 1–5) sets of neutrophil antigens recognized. The three HNA-1 antigens (a-c) are located on the low affinity Fc-γ receptor IIIb (FCGR3B :CD16b) The single known HNA-2a antigen is located on CD177. The HNA-3 antigen system has two antigens (3a and 3b) which are located on the seventh exon of the CLT2 gene (SLC44A2). The HNA-4 and HNA-5 antigen systems each have two known antigens (a and b) and are located in the β2 integrin. HNA-4 is located on the αM chain (CD11b) and HNA-5 is located on the αL integrin unit (CD11a).[70]
Subpopulations

Two functionally unequal subpopulations of neutrophils were identified on the basis of different levels of their reactive oxygen metabolite generation, membrane permeability, activity of enzyme system, and ability to be inactivated. The cells of one subpopulation with high membrane permeability (neutrophil-killers) intensively generate reactive oxygen metabolites and are inactivated in consequence of interaction with the substrate, whereas cells of another subpopulation (neutrophil-cagers) produce reactive oxygen species less intensively, don't adhere to substrate and preserve their activity.[71][72][73][74][75] Additional studies have shown that lung tumors can be infiltrated by various populations of neutrophils.[76]
Video
- A rapidly moving neutrophil can be seen taking up several conidia over an imaging time of 2 hours with one frame every 30 seconds.
- A neutrophil can be seen here selectively taking up several Candida yeasts (fluorescently labeled in green) despite several contacts with Aspergillus fumigatus conidia (unlabeled, white/clear) in a 3-D collagen matrix. Imaging time was 2 hours with one frame every 30 seconds.
Neutrophils display highly directional amoeboid motility in infected footpad and phalanges. Intravital imaging was performed in the footpad path of LysM-eGFP mice 20 minutes after infection with Listeria monocytogenes.[77]
Additional images
 Blood cell lineage
Blood cell lineage_diagram_en.svg.png) More complete lineages
More complete lineages
See also
References
- ↑ Actor J (2012). Elsevier's Integrated Review Immunology and Microbiology (Second ed.). doi:10.1016/B978-0-323-07447-6.00002-8.
- ↑ Ermert D, Niemiec MJ, Röhm M, Glenthøj A, Borregaard N, Urban CF (August 2013). "Candida albicans escapes from mouse neutrophils". Journal of Leukocyte Biology. 94 (2): 223–236. doi:10.1189/jlb.0213063. PMID 23650619. S2CID 25619835.
- ↑ Witko-Sarsat V, Rieu P, Descamps-Latscha B, Lesavre P, Halbwachs-Mecarelli L (May 2000). "Neutrophils: molecules, functions and pathophysiological aspects". Laboratory Investigation; A Journal of Technical Methods and Pathology. 80 (5): 617–653. doi:10.1038/labinvest.3780067. PMID 10830774. S2CID 22536645.
- ↑ Klebanoff SJ, Clark RA (1978). The Neutrophil: Function and Clinical Disorders. Elsevier/North-Holland Amsterdam. ISBN 978-0-444-80020-6.
- ↑ Nathan C (March 2006). "Neutrophils and immunity: challenges and opportunities". Nature Reviews. Immunology. 6 (3): 173–182. doi:10.1038/nri1785. PMID 16498448. S2CID 1590558.
- ↑ Welsh CJ (2021). Hole's Essentials of Human Anatomy and Physiology (14th ed.). New York, USA: McGraw Hill. p. 336. ISBN 978-1-260-57521-7. Retrieved 28 February 2023.
- ↑ Jacobs L, Nawrot TS, de Geus B, Meeusen R, Degraeuwe B, Bernard A, et al. (October 2010). "Subclinical responses in healthy cyclists briefly exposed to traffic-related air pollution: an intervention study". Environmental Health. 9 (64): 64. Bibcode:2010EnvHe...9...64J. doi:10.1186/1476-069X-9-64. PMC 2984475. PMID 20973949.
- ↑ Waugh DJ, Wilson C (November 2008). "The interleukin-8 pathway in cancer". Clinical Cancer Research. 14 (21): 6735–6741. doi:10.1158/1078-0432.CCR-07-4843. PMID 18980965. S2CID 9415085.
- ↑ De Larco JE, Wuertz BR, Furcht LT (August 2004). "The potential role of neutrophils in promoting the metastatic phenotype of tumors releasing interleukin-8". Clinical Cancer Research. 10 (15): 4895–4900. doi:10.1158/1078-0432.CCR-03-0760. PMID 15297389. S2CID 9782495.
- ↑ Yoo SK, Starnes TW, Deng Q, Huttenlocher A (November 2011). "Lyn is a redox sensor that mediates leukocyte wound attraction in vivo". Nature. 480 (7375): 109–112. Bibcode:2011Natur.480..109Y. doi:10.1038/nature10632. PMC 3228893. PMID 22101434.
- ↑ Barer MR (2012). "The natural history of infection". Medical Microbiology. Elsevier. pp. 168–173. doi:10.1016/b978-0-7020-4089-4.00029-9. ISBN 978-0-7020-4089-4.
- ↑ Cohen S, Burns RC (2002). Pathways of the Pulp (8th ed.). St. Louis: Mosby. p. 465.
- ↑ Huerta MÁ, Molina-Álvarez M, García MM, Tejada MA, Goicoechea C, Ghasemlou N, et al. (2024-10-25). "The role of neutrophils in pain: systematic review and meta-analysis of animal studies". Pain. doi:10.1097/j.pain.0000000000003450. ISSN 0304-3959.
- ↑ Niemiec MJ, De Samber B, Garrevoet J, Vergucht E, Vekemans B, De Rycke R, et al. (June 2015). "Trace element landscape of resting and activated human neutrophils on the sub-micrometer level". Metallomics. 7 (6): 996–1010. doi:10.1039/c4mt00346b. PMID 25832493.
- 1 2 3 Zucker-Franklin D, Greaves MF, Grossi CE, Marmont AM (1988). "Neutrophils". Atlas of Blood Cells: Function and Pathology. Vol. 1 (2nd ed.). Philadelphia: Lea & Ferbiger. ISBN 978-0-8121-1094-4.
- ↑ Karni RJ, Wangh LJ, Sanchez JA (August 2001). "Nonrandom location and orientation of the inactive X chromosome in human neutrophil nuclei". Chromosoma. 110 (4): 267–274. doi:10.1007/s004120100145. PMID 11534818. S2CID 24750407.
- ↑ Reich D, Nalls MA, Kao WH, Akylbekova EL, Tandon A, Patterson N, et al. (January 2009). "Reduced neutrophil count in people of African descent is due to a regulatory variant in the Duffy antigen receptor for chemokines gene". PLOS Genetics. 5 (1): e1000360. doi:10.1371/journal.pgen.1000360. PMC 2628742. PMID 19180233.
- 1 2 Edwards SW (1994). Biochemistry and physiology of the neutrophil. Cambridge University Press. p. 6. ISBN 978-0-521-41698-6.
- ↑ Sanchez A, Reeser JL, Lau HS, Yahiku PY, Willard RE, McMillan PJ, et al. (November 1973). "Role of sugars in human neutrophilic phagocytosis". The American Journal of Clinical Nutrition. 26 (11): 1180–1184. doi:10.1093/ajcn/26.11.1180. PMID 4748178.
These data suggest that the function and not the number of phagocytes was altered by ingestion of sugars. This implicates glucose and other simple carbohydrates in the control of phagocytosis and shows that the effects last for at least 5 hr. On the other hand, a fast of 36 or 60 hr significantly increased (P < 0.001) the phagocytic index
- ↑ Rubin-Bejerano I, Abeijon C, Magnelli P, Grisafi P, Fink GR (July 2007). "Phagocytosis by human neutrophils is stimulated by a unique fungal cell wall component". Cell Host & Microbe. 2 (1): 55–67. doi:10.1016/j.chom.2007.06.002. PMC 2083279. PMID 18005717.
- ↑ Kneller A (2007). "White blood cells are picky about sugar". Whitehead Institute. Retrieved 2013-08-09.
- ↑ Tak T, Tesselaar K, Pillay J, Borghans JA, Koenderman L (October 2013). "What's your age again? Determination of human neutrophil half-lives revisited". Journal of Leukocyte Biology. 94 (4): 595–601. doi:10.1189/jlb.1112571. PMID 23625199. S2CID 40113921.
- ↑ Pillay J, den Braber I, Vrisekoop N, Kwast LM, de Boer RJ, Borghans JA, et al. (July 2010). "In vivo labeling with 2H2O reveals a human neutrophil lifespan of 5.4 days". Blood. 116 (4): 625–627. doi:10.1182/blood-2010-01-259028. PMID 20410504. S2CID 909519.
- 1 2 Wheater PR, Stevens A (2002). Wheater's basic histopathology: a colour atlas and text. Edinburgh: Churchill Livingstone. ISBN 978-0-443-07001-3.
- ↑ Akbar N, Braithwaite AT, Corr EM, Koelwyn GJ, van Solingen C, Cochain C, et al. (March 2023). "Rapid neutrophil mobilization by VCAM-1+ endothelial cell-derived extracellular vesicles". Cardiovascular Research. 119 (1): 236–251. doi:10.1093/cvr/cvac012. PMC 10022859. PMID 35134856.
- 1 2 Ritter U, Frischknecht F, van Zandbergen G (November 2009). "Are neutrophils important host cells for Leishmania parasites?". Trends in Parasitology. 25 (11): 505–510. doi:10.1016/j.pt.2009.08.003. PMID 19762280.
- ↑ Serhan CN, Ward PA, Gilroy DW (2010). Fundamentals of Inflammation. Cambridge University Press. pp. 53–54. ISBN 978-0-521-88729-8.
- ↑ Pantarelli C, Welch HC (November 2018). "Rac-GTPases and Rac-GEFs in neutrophil adhesion, migration and recruitment". European Journal of Clinical Investigation. 48 (Suppl 2): e12939. doi:10.1111/eci.12939. PMC 6321979. PMID 29682742.
- ↑ Lin Y, Pal DS, Banerjee P, Banerjee T, Qin G, Deng Y, et al. (July 2024). "Ras suppression potentiates rear actomyosin contractility-driven cell polarization and migration". Nature Cell Biology: 1–15. doi:10.1038/s41556-024-01453-4. PMC 11364469. PMID 38951708.
- ↑ Pal DS, Banerjee T, Lin Y, de Trogoff F, Borleis J, Iglesias PA, et al. (July 2023). "Actuation of single downstream nodes in growth factor network steers immune cell migration". Developmental Cell. 58 (13): 1170–1188.e7. doi:10.1016/j.devcel.2023.04.019. PMC 10524337. PMID 37220748.
- ↑ Lämmermann T, Afonso PV, Angermann BR, Wang JM, Kastenmüller W, Parent CA, et al. (June 2013). "Neutrophil swarms require LTB4 and integrins at sites of cell death in vivo". Nature. 498 (7454): 371–375. Bibcode:2013Natur.498..371L. doi:10.1038/nature12175. PMC 3879961. PMID 23708969.
- ↑ Ear T, McDonald PP (April 2008). "Cytokine generation, promoter activation, and oxidant-independent NF-kappaB activation in a transfectable human neutrophilic cellular model". BMC Immunology. 9: 14. doi:10.1186/1471-2172-9-14. PMC 2322942. PMID 18405381.
- ↑ Ambatipudi KS, Old JM, Guilhaus M, Raftery M, Hinds L, Deane EM (2006). Proteomic analysis of the neutrophil proteins of the Tammar wallaby (Macropus eugenii). Comparative Biochemistry and Physiology. Part D: Genomic and Proteomics. 1(3), 283-291. DOI: 10.1016/j.cbd.2006.05.002
- ↑ Hickey MJ, Kubes P (May 2009). "Intravascular immunity: the host-pathogen encounter in blood vessels". Nature Reviews. Immunology. 9 (5): 364–375. doi:10.1038/nri2532. PMID 19390567. S2CID 8068543.
- ↑ Segal AW (2005). "How neutrophils kill microbes". Annual Review of Immunology. 23 (5): 197–223. doi:10.1146/annurev.immunol.23.021704.115653. PMC 2092448. PMID 15771570.
- ↑ Simons MP, Nauseef WM, Griffith TS, Apicella MA (November 2006). "Neisseria gonorrhoeae delays the onset of apoptosis in polymorphonuclear leukocytes". Cellular Microbiology. 8 (11): 1780–1790. doi:10.1111/j.1462-5822.2006.00748.x. PMID 16803582. S2CID 25253422.
- ↑ Chen A, Seifert HS (November 2011). "Neisseria gonorrhoeae-mediated inhibition of apoptotic signalling in polymorphonuclear leukocytes". Infection and Immunity. 79 (11): 4447–4458. doi:10.1128/IAI.01267-10. PMC 3257915. PMID 21844239.
- ↑ van Zandbergen G, Gieffers J, Kothe H, Rupp J, Bollinger A, Aga E, et al. (February 2004). "Chlamydia pneumoniae multiply in neutrophil granulocytes and delay their spontaneous apoptosis". Journal of Immunology. 172 (3): 1768–1776. doi:10.4049/jimmunol.172.3.1768. PMID 14734760. S2CID 27422510.
- ↑ Kobayashi SD, Braughton KR, Whitney AR, Voyich JM, Schwan TG, Musser JM, et al. (September 2003). "Bacterial pathogens modulate an apoptosis differentiation program in human neutrophils". Proceedings of the National Academy of Sciences of the United States of America. 100 (19): 10948–10953. doi:10.1073/pnas.1833375100. PMC 196908. PMID 12960399.
- ↑ Kobayashi SD, Malachowa N, DeLeo FR (2017). "Influence of Microbes on Neutrophil Life and Death". Frontiers in Cellular and Infection Microbiology. 7 (159): 159. doi:10.3389/fcimb.2017.00159. PMC 5410578. PMID 28507953.
 Material was copied from this source, which is available under a Creative Commons Attribution 4.0 International License.
Material was copied from this source, which is available under a Creative Commons Attribution 4.0 International License. - ↑ Berman LB, Feys JO, Schreiner GE (November 1956). "Observations on the glitter-cell phenomenon". The New England Journal of Medicine. 255 (21): 989–991. doi:10.1056/NEJM195611222552104. PMID 13378597.
- ↑ Sengelov H, Kjedsen L, Borregaard N (February 1993). "Control of exocytosis in early neutrophil activation". Journal of Immunology. 150 (4): 1535–43. PMID 8381838.
- ↑ Ringel EW, Soter NA, Austen KF (August 1984). "Localization of histaminase to the specific granule of the human neutrophil". Immunology. 52 (4): 649–658. PMC 1454675. PMID 6430792.
- ↑ Brinkmann V, Reichard U, Goosmann C, Fauler B, Uhlemann Y, Weiss DS, et al. (March 2004). "Neutrophil extracellular traps kill bacteria". Science. 303 (5663): 1532–1535. Bibcode:2004Sci...303.1532B. doi:10.1126/science.1092385. PMID 15001782. S2CID 21628300.
- ↑ Urban CF, Ermert D, Schmid M, Abu-Abed U, Goosmann C, Nacken W, et al. (October 2009). "Neutrophil extracellular traps contain calprotectin, a cytosolic protein complex involved in host defense against Candida albicans". PLOS Pathogens. 5 (10): e1000639. doi:10.1371/journal.ppat.1000639. PMC 2763347. PMID 19876394.
- ↑ Clark SR, Ma AC, Tavener SA, McDonald B, Goodarzi Z, Kelly MM, et al. (April 2007). "Platelet TLR4 activates neutrophil extracellular traps to ensnare bacteria in septic blood". Nature Medicine. 13 (4): 463–469. doi:10.1038/nm1565. PMID 17384648. S2CID 22372863.
- ↑ Monteith AJ, Miller JM, Maxwell CN, Chazin WJ, Skaar EP (September 2021). "Neutrophil extracellular traps enhance macrophage killing of bacterial pathogens". Science Advances. 7 (37): eabj2101. Bibcode:2021SciA....7.2101M. doi:10.1126/sciadv.abj2101. PMC 8442908. PMID 34516771.
- ↑ Monteith AJ, Miller JM, Beavers WN, Maloney KN, Seifert EL, Hajnoczky G, et al. (February 2022). "Mitochondrial Calcium Uniporter Affects Neutrophil Bactericidal Activity during Staphylococcus aureus Infection". Infection and Immunity. 90 (2): e0055121. doi:10.1128/IAI.00551-21. PMC 8853686. PMID 34871043.
- ↑ Gupta AK, Hasler P, Holzgreve W, Hahn S (June 2007). "Neutrophil NETs: a novel contributor to preeclampsia-associated placental hypoxia?". Seminars in Immunopathology. 29 (2): 163–167. doi:10.1007/s00281-007-0073-4. PMID 17621701. S2CID 12887059.
- ↑ Hoyer FF, Nahrendorf M (February 2017). "Neutrophil contributions to ischaemic heart disease". European Heart Journal. 38 (7): 465–472. doi:10.1093/eurheartj/ehx017. PMID 28363210.
- ↑ Mangold A, Alias S, Scherz T, Hofbauer M, Jakowitsch J, Panzenböck A, et al. (March 2015). "Coronary neutrophil extracellular trap burden and deoxyribonuclease activity in ST-elevation acute coronary syndrome are predictors of ST-segment resolution and infarct size". Circulation Research. 116 (7): 1182–1192. doi:10.1161/CIRCRESAHA.116.304944. PMID 25547404. S2CID 2532741.
- ↑ Fuchs TA, Brill A, Duerschmied D, Schatzberg D, Monestier M, Myers DD, et al. (September 2010). "Extracellular DNA traps promote thrombosis". Proceedings of the National Academy of Sciences of the United States of America. 107 (36): 15880–15885. Bibcode:2010PNAS..10715880F. doi:10.1073/pnas.1005743107. PMC 2936604. PMID 20798043.
- ↑ Brill A, Fuchs TA, Savchenko AS, Thomas GM, Martinod K, De Meyer SF, et al. (January 2012). "Neutrophil extracellular traps promote deep vein thrombosis in mice". Journal of Thrombosis and Haemostasis. 10 (1): 136–144. doi:10.1111/j.1538-7836.2011.04544.x. PMC 3319651. PMID 22044575.
- ↑ Borissoff JI, ten Cate H (September 2011). "From neutrophil extracellular traps release to thrombosis: an overshooting host-defense mechanism?". Journal of Thrombosis and Haemostasis. 9 (9): 1791–1794. doi:10.1111/j.1538-7836.2011.04425.x. PMID 21718435. S2CID 5368241.
- ↑ Zuo Y, Yalavarthi S, Shi H, Gockman K, Zuo M, Madison JA, et al. (June 2020). "Neutrophil extracellular traps in COVID-19". JCI Insight. 5 (11): e138999. doi:10.1172/jci.insight.138999. PMC 7308057. PMID 32329756. S2CID 216109364.
- 1 2 Ancey PB, Contat C, Boivin G, Sabatino S, Pascual J, Zangger N, et al. (May 2021). "GLUT1 Expression in Tumor-Associated Neutrophils Promotes Lung Cancer Growth and Resistance to Radiotherapy". Cancer Research. 81 (9): 2345–2357. doi:10.1158/0008-5472.CAN-20-2870. PMC 8137580. PMID 33753374.
- ↑ Azevedo PO, Paiva AE, Santos GS, Lousado L, Andreotti JP, Sena IF, et al. (December 2018). "Cross-talk between lung cancer and bones results in neutrophils that promote tumor progression". Cancer and Metastasis Reviews. 37 (4): 779–790. doi:10.1007/s10555-018-9759-4. PMC 6358512. PMID 30203108.
- ↑ Kawabata K, Hagio T, Matsuoka S (September 2002). "The role of neutrophil elastase in acute lung injury". European Journal of Pharmacology. 451 (1): 1–10. doi:10.1016/S0014-2999(02)02182-9. PMID 12223222.
- ↑ Domon H, Nagai K, Maekawa T, Oda M, Yonezawa D, Takeda W, et al. (2018). "Neutrophil Elastase Subverts the Immune Response by Cleaving Toll-Like Receptors and Cytokines in Pneumococcal Pneumonia". Frontiers in Immunology. 9: 732. doi:10.3389/fimmu.2018.00732. PMC 5996908. PMID 29922273.
- ↑ Ozen S (July 2003). "Familial mediterranean fever: revisiting an ancient disease". European Journal of Pediatrics. 162 (7–8): 449–454. doi:10.1007/s00431-003-1223-x. PMID 12751000. S2CID 3464945.
- ↑ Xiu F, Stanojcic M, Diao L, Jeschke MG (8 May 2014). "Stress hyperglycemia, insulin treatment, and innate immune cells". International Journal of Endocrinology. 2014: 486403. doi:10.1155/2014/486403. PMC 4034653. PMID 24899891.
- ↑ Al-Gwaiz LA, Babay HH (2007). "The diagnostic value of absolute neutrophil count, band count and morphologic changes of neutrophils in predicting bacterial infections". Medical Principles and Practice. 16 (5): 344–347. doi:10.1159/000104806. PMID 17709921. S2CID 5499290.
- ↑ Khan HA, Alhomida AS, Sobki SH, Moghairi AA, Koronki HE (2012). "Blood cell counts and their correlation with creatine kinase and C-reactive protein in patients with acute myocardial infarction". International Journal of Clinical and Experimental Medicine. 5 (1): 50–55. PMC 3272686. PMID 22328948.
- ↑ Basili S, Di Francoi M, Rosa A, Ferroni P, Diurni V, Scarpellini MG, et al. (April 2004). "Absolute neutrophil counts and fibrinogen levels as an aid in the early diagnosis of acute myocardial infarction". Acta Cardiologica. 59 (2): 135–140. doi:10.2143/ac.59.2.2005167. PMID 15139653. S2CID 37382677.
- ↑ Grune J, Lewis AJ, Yamazoe M, Hulsmans M, Rohde D, Xiao L, et al. (July 2022). "Neutrophils incite and macrophages avert electrical storm after myocardial infarction". Nature Cardiovascular Research. 1 (7): 649–664. doi:10.1038/s44161-022-00094-w. PMC 9410341. PMID 36034743.
- ↑ Michaud K, Basso C, d'Amati G, Giordano C, Kholová I, Preston SD, et al. (February 2020). "Diagnosis of myocardial infarction at autopsy: AECVP reappraisal in the light of the current clinical classification". Virchows Archiv. 476 (2): 179–194. doi:10.1007/s00428-019-02662-1. PMC 7028821. PMID 31522288.
"This article is distributed under the terms of the Creative Commons Attribution 4.0 International License (http://creativecommons.org/licenses/by/4.0/ Archived 2015-11-21 at the Wayback Machine)" - ↑ Jickling GC, Liu D, Ander BP, Stamova B, Zhan X, Sharp FR (June 2015). "Targeting neutrophils in ischemic stroke: translational insights from experimental studies". Journal of Cerebral Blood Flow and Metabolism. 35 (6): 888–901. doi:10.1038/jcbfm.2015.45. PMC 4640255. PMID 25806703.
- 1 2 Kobayashi SD, Malachowa N, DeLeo FR (2018). "Neutrophils and Bacterial Immune Evasion". Journal of Innate Immunity. 10 (5–6): 432–441. doi:10.1159/000487756. PMC 6784029. PMID 29642066.
- 1 2 3 4 Parker HA, Forrester L, Kaldor CD, Dickerhof N, Hampton MB (2021-12-23). "Antimicrobial Activity of Neutrophils Against Mycobacteria". Frontiers in Immunology. 12: 782495. doi:10.3389/fimmu.2021.782495. PMC 8732375. PMID 35003097.
- ↑ Chu HT, Lin H, Tsao TT, Chang CF, Hsiao WW, Yeh TJ, et al. (September 2013). "Genotyping of human neutrophil antigens (HNA) from whole genome sequencing data". BMC Medical Genomics. 6 (1): 31. doi:10.1186/1755-8794-6-31. PMC 3849977. PMID 24028078.
 This article incorporates text available under the CC BY 2.0 license.
This article incorporates text available under the CC BY 2.0 license. - 1 2 Ignatov DY (2012). Functional heterogeneity of human neutrophils and their role in peripheral blood leukocyte quantity regulation (PhD). Donetsk National Medical University. doi:10.13140/RG.2.2.35542.34884.
- ↑ Gerasimov IG, Ignatov DI (2001). "[Functional heterogenicity of human blood neutrophils: generation of oxygen active species]". Tsitologiia. 43 (5): 432–436. PMID 11517658.
- ↑ Gerasimov IG, Ignatov DI (2004). "[Neutrophil activation in vitro]". Tsitologiia. 46 (2): 155–158. PMID 15174354.
- ↑ Gerasimov IG, Ignatov DI, Kotel'nitskiĭ MA (2005). "[Nitroblue tetrazolium reduction by human blood neutrophils. I. The influence of pH]". Tsitologiia. 47 (6): 549–553. PMID 16708848.
- ↑ Gerasimov IG, Ignatov DI (2005). "[Nitroblue tetrazolium reduction by human blood neutrophils. II. The influence of sodium and potassium ions]". Tsitologiia. 47 (6): 554–558. PMID 16708849.
- ↑ Zilionis R, Engblom C, Pfirschke C, Savova V, Zemmour D, Saatcioglu HD, et al. (May 2019). "Single-Cell Transcriptomics of Human and Mouse Lung Cancers Reveals Conserved Myeloid Populations across Individuals and Species". Immunity. 50 (5): 1317–1334.e10. doi:10.1016/j.immuni.2019.03.009. PMC 6620049. PMID 30979687.
- ↑ Graham DB, Zinselmeyer BH, Mascarenhas F, Delgado R, Miller MJ, Swat W (2009). Unutmaz D (ed.). "ITAM signaling by Vav family Rho guanine nucleotide exchange factors regulates interstitial transit rates of neutrophils in vivo". PLOS ONE. 4 (2): e4652. Bibcode:2009PLoSO...4.4652G. doi:10.1371/journal.pone.0004652. PMC 2645696. PMID 19247495.
External links
- Neutropenia Information (Archived 2015-12-02 at the Wayback Machine)
- Absolute Neutrophil Count Calculator
- Neutrophil Trace Element Content and Distribution